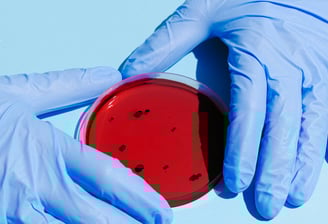

Odkryj tajemnice przyrody
z nami
Zadowolenie naszych małych detektywów
★★★★★
Nauka przez zabawę i eksperymenty
Zapisz swoje dziecko na wyjątkowe warsztaty, które łączą naukę z doskonałą zabawą!
Nasze zajęcia wciągają dzieci
w fascynujący świat przyrody poprzez kreatywne i samodzielne eksperymenty
i interaktywne zadania.


Edukacja Przyrodnicza
Oferujemy programy edukacyjne dla dzieci, odkrywające tajemnice roślin
i zwierząt w przyrodzie.
Warsztaty Przyrodnicze
Interaktywne warsztaty dla dzieci, które rozwijają ich zainteresowania przyrodnicze poprzez zabawę.


Materiały Edukacyjne
Korzystamy z materiałów edukacyjnych
i sprzętów, które są bezpieczne dla dzieci
i angażują je w naukę.
Przeprowadzamy eksperymenty, gdzie dzieci uczą się samodzielności oraz krytycznego
i analitycznego myślenia.
Eksperymenty

Uczymy dzieci o przyrodzie
i eksperymentach.
Kontakt
isaura.felcenloben@gmail.com
+48 508 839 223
© 2025. All rights reserved.
